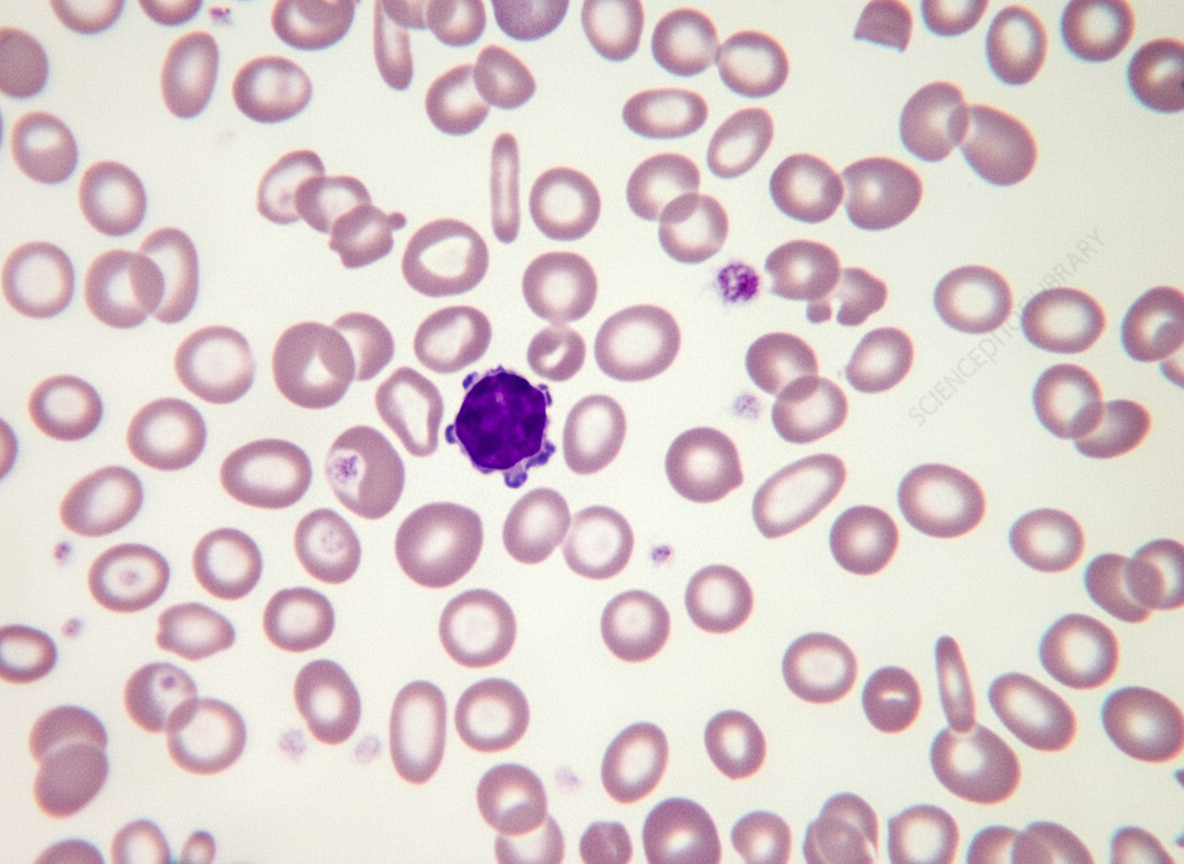
Image for question 58

Which of the following is most useful in the treatment of Kostmann's Syndrome?
Which chelating agent is used in chronic thalassemia major for iron overload?
A mother brings her 2-year-old boy with a history of pallor. Examination reveals pallor, petechiae, and splenomegaly. Which of the following is the most likely diagnosis?
Aplastic anemia with skeletal abnormalities, short stature, and pancreatic exocrine failure suggests which diagnosis?
Salmonellosis is most common in which of the following conditions?
Which of the following is characteristic of Fanconi Anemia?
In Sickle cell disease, aplastic crisis is due to which type of infection?
The peripheral blood smear of an anemic 1-year-old child is shown in the illustration. The most likely diagnosis is?
A 10-year-old boy presents with mucosal bleeding of 1 week's duration. Which investigation is most useful in this patient?
A newborn baby presented with profuse bleeding from the umbilical stump. What is the probable diagnosis?
Explanation: **Explanation:** **Kostmann’s Syndrome** (Severe Congenital Neutropenia) is an autosomal recessive disorder characterized by a maturation arrest of neutrophil precursors in the bone marrow at the promyelocyte stage. This leads to absolute neutrophil counts (ANC) frequently below 200/µL, making patients highly susceptible to life-threatening bacterial infections. **Why Filgrastim is the Correct Answer:** **Filgrastim** is a recombinant **Granulocyte Colony-Stimulating Factor (G-CSF)**. It is the mainstay of treatment because it bypasses the maturation arrest, stimulating the production and release of functional neutrophils from the bone marrow. Long-term G-CSF therapy has revolutionized the prognosis of Kostmann’s syndrome, significantly reducing infectious morbidity. **Analysis of Incorrect Options:** * **A. Sargramostim:** This is a recombinant **GM-CSF** (Granulocyte-Macrophage CSF). While it stimulates neutrophils, it also affects monocytes and eosinophils, often leading to more systemic side effects (like bone pain and fever) without being more effective than G-CSF for this specific condition. * **B. Aldesleukin:** This is a recombinant **Interleukin-2 (IL-2)** used primarily in the treatment of metastatic renal cell carcinoma and melanoma. It promotes T-cell proliferation and has no role in treating neutropenia. * **C. Oprelvekin:** This is a recombinant **Interleukin-11 (IL-11)** used to treat chemotherapy-induced **thrombocytopenia** by stimulating megakaryocyte proliferation. **High-Yield Clinical Pearls for NEET-PG:** * **Genetics:** The most common mutation in Kostmann’s syndrome is in the **HAX1 gene** (though *ELANE* mutations are the most common cause of severe congenital neutropenia overall). * **Bone Marrow Finding:** Characterized by **"Maturation Arrest"** at the promyelocyte/myelocyte stage. * **Malignancy Risk:** Patients with Kostmann’s syndrome have an increased risk of developing **Acute Myeloid Leukemia (AML)** or Myelodysplastic Syndrome (MDS). * **Definitive Cure:** Hematopoietic Stem Cell Transplant (HSCT) is the only curative treatment for those refractory to G-CSF.
Explanation: **Explanation:** In patients with Thalassemia Major, chronic blood transfusions lead to secondary iron overload (hemosiderosis). Since the human body lacks an active mechanism to excrete excess iron, chelation therapy is mandatory once ferritin levels exceed 1000 ng/ml or after 10–20 transfusions. **Why Deferiprone is correct:** **Deferiprone** is an **oral** iron chelator. It is highly effective and particularly noted for its ability to remove iron from the myocardium, making it superior in preventing iron-induced heart failure. In the context of the options provided, it is a standard agent used for chronic management. **Analysis of Incorrect Options:** * **A. Oral Desferroxamine:** This is incorrect because **Desferroxamine (DFO) is not orally active.** It has poor gastrointestinal absorption and must be administered parenterally. * **B. EDTA:** Ethylene Diamine Tetra-acetic Acid is primarily used for **lead poisoning**, not for chronic iron overload in thalassemia. * **D. Intravenous Deferoxamine:** While Deferoxamine is used for iron overload, it is typically administered via **slow subcutaneous infusion** (over 8–12 hours) rather than bolus intravenous injection for chronic management. Furthermore, oral agents like Deferiprone or Deferasirox are often preferred for better patient compliance in chronic settings. **High-Yield Clinical Pearls for NEET-PG:** * **Deferoxamine:** Side effects include ototoxicity (high-frequency hearing loss) and retinal toxicity. * **Deferiprone:** The most serious side effect is **agranulocytosis/neutropenia**; regular monitoring of Absolute Neutrophil Count (ANC) is required. * **Deferasirox:** A once-daily oral chelator; currently the most commonly used agent due to its long half-life and ease of administration. * **Drug of Choice for Acute Iron Poisoning:** Intravenous Deferoxamine.
Explanation: ### Explanation The clinical triad of **pallor, petechiae, and splenomegaly** in a young child is a classic presentation of **Acute Leukemia** (most commonly Acute Lymphoblastic Leukemia - ALL in this age group). #### Why Acute Leukemia is Correct: The underlying mechanism is **bone marrow infiltration** by malignant blast cells. This leads to: 1. **Anemia:** Causing pallor. 2. **Thrombocytopenia:** Leading to petechiae and mucosal bleeding. 3. **Extramedullary involvement:** Infiltration of the liver and spleen results in hepatosplenomegaly. The presence of both cytopenias (anemia + thrombocytopenia) and organomegaly strongly points toward a bone marrow malignancy rather than a simple nutritional deficiency or isolated platelet disorder. #### Why Other Options are Incorrect: * **Thalassaemia:** While it presents with severe pallor and massive splenomegaly (due to extramedullary hematopoiesis), it does **not** cause thrombocytopenia or petechiae. In fact, platelet counts are usually normal or elevated. * **Hodgkin’s Lymphoma:** Typically presents with painless lymphadenopathy (often cervical). While splenomegaly can occur, it rarely presents with acute bone marrow failure (petechiae) in the early stages. * **Idiopathic Thrombocytopenic Purpura (ITP):** While ITP causes petechiae, the **spleen is typically NOT palpable**. If splenomegaly is present, an alternative diagnosis like leukemia must be ruled out. Furthermore, ITP does not cause anemia (pallor) unless there is significant hemorrhage. #### NEET-PG High-Yield Pearls: * **ALL** is the most common childhood malignancy (Peak age: 2–5 years). * **Diagnostic Gold Standard:** Bone marrow aspiration showing >20% blasts. * **Prognostic Marker:** Presence of the Philadelphia chromosome t(9;22) indicates a poor prognosis in ALL. * **Clinical Clue:** Bone pain (refusal to walk) in a pale child with petechiae is a high-yield indicator for Leukemia.
Explanation: **Explanation:** **Shwachman-Diamond Syndrome (SDS)** is the correct diagnosis because it is classically characterized by the triad of **pancreatic exocrine insufficiency** (presenting as malabsorption/steatorrhea), **bone marrow failure** (initially neutropenia, progressing to aplastic anemia), and **skeletal abnormalities** (metaphyseal dysostosis and short stature). It is the second most common cause of inherited pancreatic insufficiency after Cystic Fibrosis. **Analysis of Incorrect Options:** * **Fanconi Anemia:** While it presents with aplastic anemia, short stature, and skeletal defects (classically **absent/hypoplastic radii or thumbs**), it does **not** involve pancreatic exocrine failure. It is also associated with hyperpigmentation (café-au-lait spots). * **Diamond-Blackfan Anemia:** This is a **pure red cell aplasia** (not global aplasia) presenting in infancy. While it features skeletal anomalies (triphalangeal thumbs), it lacks pancreatic involvement and neutropenia. * **G6PD Deficiency:** This is an enzyme defect causing **episodic hemolytic anemia** triggered by oxidative stress (fava beans, infections). It does not cause bone marrow failure or skeletal malformations. **High-Yield Clinical Pearls for NEET-PG:** * **SDS Genetics:** Most cases are due to mutations in the **SBDS gene** (Autosomal Recessive). * **Differentiating SDS from Cystic Fibrosis:** SDS patients have a **normal sweat chloride test** despite pancreatic symptoms. * **Malignancy Risk:** Patients with SDS have a significantly increased risk of developing **Myelodysplastic Syndrome (MDS)** and **Acute Myeloid Leukemia (AML)**. * **Lab Hallmark:** Intermittent or persistent **neutropenia** is often the earliest hematologic sign.
Explanation: **Explanation:** **Sickle Cell Anemia (SCA)** is the correct answer because patients with this condition are uniquely predisposed to invasive infections by *Salmonella* species, particularly **Salmonella osteomyelitis**. This susceptibility is due to several pathophysiological factors: 1. **Functional Hyposplenism:** Recurrent splenic infarcts lead to "autosplenectomy," impairing the clearance of encapsulated organisms and intracellular pathogens like *Salmonella*. 2. **Bowel Infarcts:** Microvascular occlusion in the gut wall allows *Salmonella* (normal flora or transient) to translocate into the bloodstream. 3. **Expanded Bone Marrow:** Chronic hemolysis leads to expanded, sluggish medullary blood flow and areas of bone necrosis (infarcts), providing an ideal nidus for bacterial seeding. **Analysis of Incorrect Options:** * **B. Thalassemia:** While these patients are prone to infections due to iron overload (siderophilic bacteria like *Yersinia*) and splenectomy, *Salmonella* is not specifically characteristic of Thalassemia compared to SCA. * **C. Hemophilia:** This is a coagulation disorder. Patients are at risk for transfusion-transmitted infections (HIV, Hepatitis), but not specifically *Salmonella*. * **D. Cystic Fibrosis:** These patients are primarily predisposed to respiratory infections, most notably *Pseudomonas aeruginosa* and *Staphylococcus aureus*. **High-Yield Clinical Pearls for NEET-PG:** * **Most common cause of Osteomyelitis in SCA:** *Salmonella* (unique to SCA), though *Staph. aureus* remains a frequent cause globally. * **Most common cause of Osteomyelitis in the general population:** *Staphylococcus aureus*. * **Most common cause of death in SCA children:** Sepsis due to *Streptococcus pneumoniae*. * **Prophylaxis:** Daily Oral Penicillin is recommended for children with SCA until age 5 to prevent pneumococcal sepsis.
Explanation: **Explanation:** **Fanconi Anemia (FA)** is the most common cause of inherited bone marrow failure. The underlying pathophysiology involves a defect in the **DNA repair mechanism**, specifically the inability to repair interstrand cross-links. 1. **Why Option B is Correct:** Because of the defective DNA repair, cells from FA patients are hypersensitive to DNA cross-linking agents. When exposed to **Diepoxybutane (DEB) or Mitomycin C (MMC)**, their chromosomes exhibit characteristic breakage, gaps, and rearrangements (radial forms). This "Chromosomal Breakage Study" is the **gold standard diagnostic test** for Fanconi Anemia. 2. **Why Other Options are Incorrect:** * **Option A:** FA is primarily an **Autosomal Recessive** condition (though rare X-linked and autosomal dominant subtypes exist). * **Option C:** It is a pediatric condition, typically presenting between **5 to 10 years of age** with signs of hematologic failure. * **Option D:** The bone marrow in FA is **hypocellular** (Aplastic Anemia), as the hematopoietic stem cells are progressively depleted. **High-Yield Clinical Pearls for NEET-PG:** * **Physical Findings:** Short stature, **absent/hypoplastic radii and thumbs**, microcephaly, and **Café-au-lait spots**. * **Hematology:** Macrocytosis (high MCV) is often the earliest sign before the onset of full pancytopenia. * **Malignancy Risk:** Patients have a significantly increased risk of **AML** and squamous cell carcinomas (head, neck, and anogenital). * **Treatment:** Hematopoietic Stem Cell Transplant (HSCT) is the definitive treatment for hematologic complications.
Explanation: **Explanation:** In Sickle Cell Disease (SCD), the lifespan of a red blood cell (RBC) is significantly reduced (10–20 days compared to the normal 120 days). To maintain hemoglobin levels, the bone marrow must work at maximum capacity. **Parvovirus B19** is the correct answer because it specifically targets and destroys **erythroid progenitor cells** in the bone marrow by binding to the P-antigen. In healthy individuals, a brief pause in RBC production is clinically silent. However, in SCD patients, this sudden cessation of erythropoiesis leads to a rapid drop in hemoglobin and a disappearance of reticulocytes from the peripheral blood, resulting in a life-threatening **Aplastic Crisis**. **Analysis of Incorrect Options:** * **A. Herpes infection:** Herpes simplex viruses typically cause mucocutaneous lesions or encephalitis; they do not specifically target erythroid precursors. * **B. Measles infection:** Measles causes respiratory symptoms and a characteristic maculopapular rash (Koplik spots) but is not associated with bone marrow suppression in SCD. * **D. Rubella infection:** While Rubella can cause congenital defects or a mild febrile illness with rash, it does not trigger aplastic crises. **High-Yield Clinical Pearls for NEET-PG:** * **Hallmark of Aplastic Crisis:** Severe anemia + **Reticulocytopenia** (Reticulocyte count <1%). This distinguishes it from a Hyperhemolytic crisis where reticulocytes are elevated. * **Diagnosis:** Detection of Parvovirus B19 IgM antibodies or PCR for viral DNA. * **Management:** Urgent blood transfusion is the mainstay of treatment. * **Other Crises in SCD:** Vaso-occlusive crisis (most common), Splenic Sequestration (sudden splenomegaly + drop in Hb), and Acute Chest Syndrome.
Explanation: ***Iron deficiency anemia*** - The peripheral blood smear shows **microcytic hypochromic RBCs** with **increased central pallor** and **pencil cells** (cigar-shaped cells), which are characteristic findings in iron deficiency anemia. - This is the most common cause of anemia in **1-year-old children** due to rapid growth, inadequate dietary iron intake, and transition from breast milk to solid foods. *Anemia of chronic disease* - Typically presents with **normocytic normochromic** RBCs or mildly microcytic cells, not the severe microcytosis and hypochromia seen here. - Usually associated with underlying **chronic inflammatory conditions** like infections or autoimmune diseases, which are less common in healthy 1-year-olds. *Aplastic anemia* - Characterized by **pancytopenia** (decreased RBCs, WBCs, and platelets) with **normocytic normochromic** RBCs on peripheral smear. - The peripheral smear would show **reduced cell counts** across all lineages, not the microcytic hypochromic picture described. *Hereditary spherocytosis* - Shows **spherocytes** (round RBCs lacking central pallor) and **polychromasia** due to increased reticulocyte production from hemolysis. - Associated with **splenomegaly** and **unconjugated hyperbilirubinemia**, presenting with jaundice rather than the microcytic pattern seen here.
Explanation: **Explanation:** The clinical presentation of **mucosal bleeding** (such as epistaxis, gum bleeding, or petechiae) is a hallmark of **primary hemostasis** defects. Primary hemostasis involves the formation of a platelet plug and is dependent on adequate platelet numbers and function. Therefore, a **Platelet count** is the most useful initial investigation to rule out thrombocytopenia (e.g., ITP, which is common in children). **Why the other options are incorrect:** * **Prothrombin Time (PT):** Measures the extrinsic and common pathways of the coagulation cascade. Deficiencies here typically present with deep-seated bleeds (hematomas or hemarthrosis), not superficial mucosal bleeding. * **Partial Thromboplastin Time (PTT):** Measures the intrinsic and common pathways. Like PT, it assesses secondary hemostasis. Prolonged PTT is seen in conditions like Hemophilia, which rarely presents with isolated mucosal bleeding. * **Clotting Time (CT):** This is an obsolete, insensitive test with poor reproducibility. It only becomes prolonged in severe coagulation factor deficiencies and is not used in modern clinical practice. **NEET-PG Clinical Pearls:** * **Primary Hemostasis Defect:** Characterized by mucosal bleeding, petechiae, purpura, and immediate bleeding after injury. (Tests: Platelet count, Bleeding Time/PFA-100). * **Secondary Hemostasis Defect:** Characterized by deep muscle hematomas, hemarthrosis (joint bleeds), and delayed bleeding. (Tests: PT, aPTT). * **Von Willebrand Disease (vWD):** The most common inherited bleeding disorder; it is a unique "hybrid" that often presents with mucosal bleeding because vWF is required for platelet adhesion.
Explanation: **Explanation:** The clinical presentation of profuse bleeding from the umbilical stump in a newborn is a classic "high-yield" sign for **Factor XIII (Fibrin Stabilizing Factor) deficiency**. **Why Factor XIII deficiency is correct:** Factor XIII is responsible for cross-linking fibrin polymers to form a stable, insoluble clot. In its absence, a primary clot forms but is unstable and undergoes premature lysis. The umbilical stump is a unique site where physiological clot stability is tested early; hence, delayed umbilical bleeding (often occurring 24–48 hours after birth) is the hallmark presentation in approximately 80% of affected neonates. **Why the other options are incorrect:** * **Von Willebrand Disease (vWD):** This is a disorder of platelet adhesion. While it causes mucosal bleeding (epistaxis, menorrhagia), it rarely presents with umbilical stump bleeding in the neonatal period. * **Factor XII Deficiency (Hageman factor):** Paradoxically, this deficiency leads to a prolonged aPTT in the lab but **no clinical bleeding tendency** in the patient. It is usually an incidental finding. * **Glanzmann Thrombosthenia:** This is a qualitative platelet disorder (deficiency of GpIIb/IIIa). It typically presents with purpura, petechiae, and mucosal bleeds rather than isolated umbilical stump hemorrhage. **Clinical Pearls for NEET-PG:** * **The "Clot Solubility Test":** Standard coagulation profiles (PT, aPTT, Bleeding Time) are **normal** in Factor XIII deficiency. Diagnosis is confirmed by the 5-Molar Urea Clot Solubility Test (the clot dissolves rapidly in urea). * **Complications:** Factor XIII deficiency has the highest risk of spontaneous intracranial hemorrhage among all bleeding disorders. * **Poor Wound Healing:** Factor XIII is also essential for fibroblast proliferation; thus, patients often exhibit abnormal scar formation.
Anemias in Children
Practice Questions
Hemoglobinopathies
Practice Questions
Hemolytic Anemias
Practice Questions
Nutritional Anemias
Practice Questions
Thrombocytopenia
Practice Questions
Bleeding Disorders
Practice Questions
Thrombotic Disorders
Practice Questions
White Blood Cell Disorders
Practice Questions
Bone Marrow Failure Syndromes
Practice Questions
Blood Component Therapy
Practice Questions
Hemophilia and Von Willebrand Disease
Practice Questions
Evaluation of Bleeding Tendencies
Practice Questions
Get full access to all questions, explanations, and performance tracking.
Start For Free